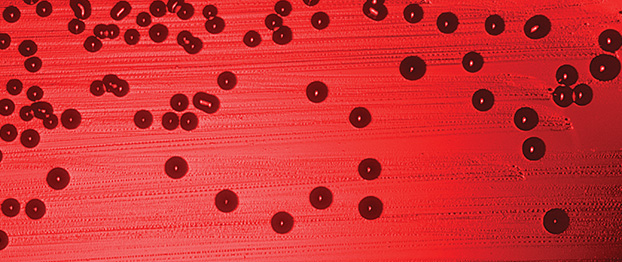

Streszczenie
Sepsa, inaczej posocznica, budzi wśród ludzi lęk. Często mylona jest z innymi rodzajami zakażeń, np. bakteriemią. Od 1991 roku funkcjonują ściśle określone definicje i kryteria rozpoznania sepsy. Ze względu na słabo rozwinięty układ odpornościowy, jedną z najbardziej zagrożonych sepsą grup pacjentów są dzieci do piątego roku życia. Posocznica może u nich wystąpić nawet po zastosowaniu zanieczyszczonych mikroorganizmami kosmetyków.
Słowa kluczowe: sepsa, infekcja, pałeczki gram-ujemne, Salmonella sp., RAS
Abstract
Sepsis is a word arousing fear among the people. However, it is often confused with other terms such as bacteremia. Since 1991 there are restricted definitions and diagnostic criteria for sepsis. Due to the under-developed immune system, one of the most endangered groups of septic patients are children under 5 years of age. In their case, sepsis can occur after applying cosmetics contaminated with microorganisms.
Key words: sepsis, infection, gram-negative rods, Salmonella sp., RAS
Aleksandra Pawlak
Zakład Mikrobiologii, Instytut Genetyki i Mikrobiologii, Uniwersytet Wrocławski
Czytaj całość: Kosmetologia Estetyczna, 2 (1), 2013, 65-67